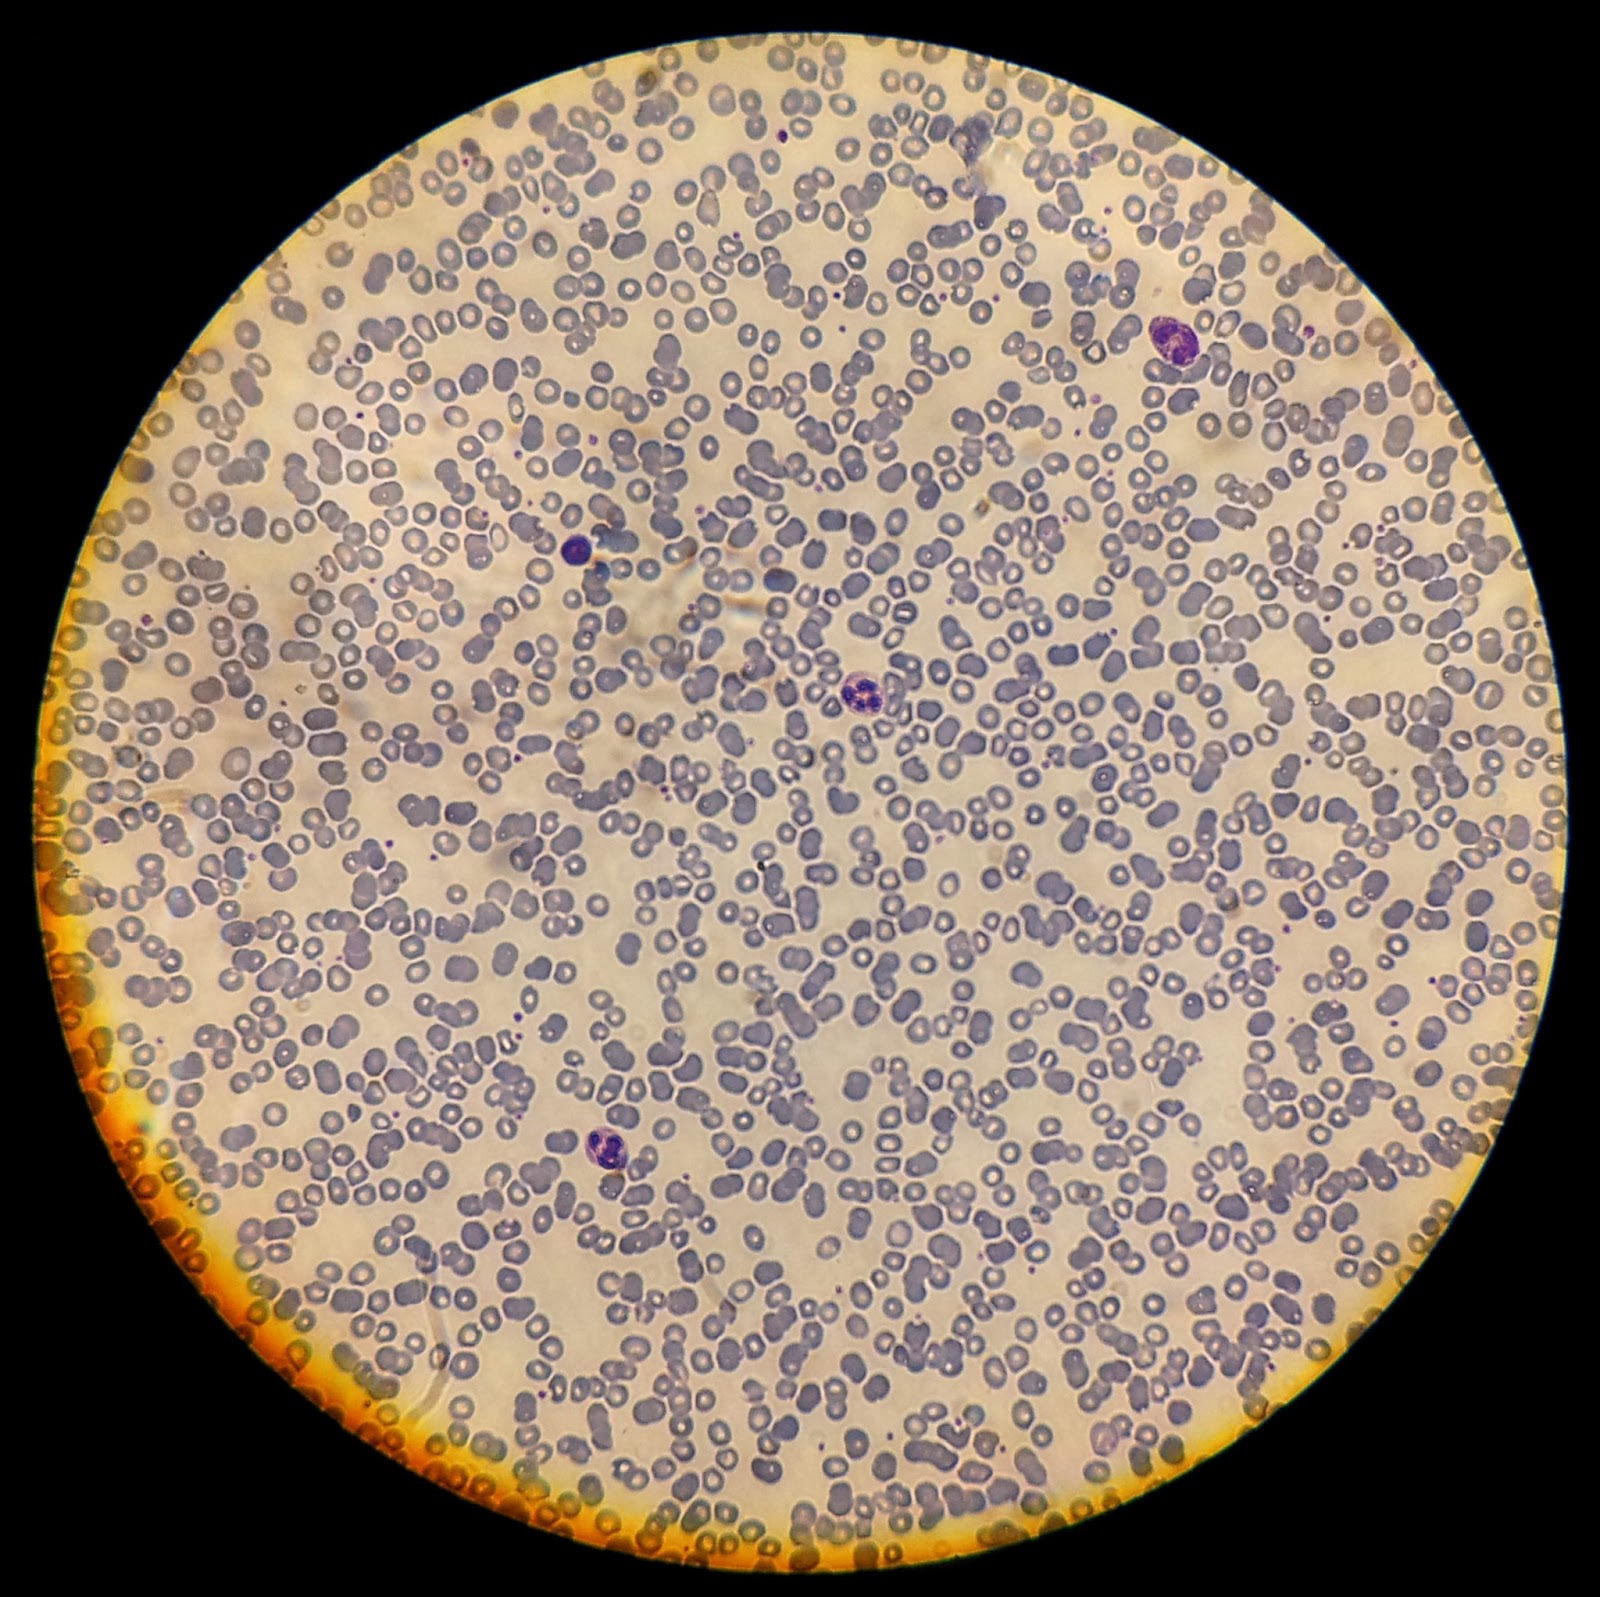

No obstante, la mayoría de células no son perceptibles a simple vista, para poder observarlas se necesitan espejos compuestos, es decir, un micróscopio. Nuestros ojos, la igual que el resto de nuestro cuerpo está compuesto de células, para la óptica humana no es posible observar estas diminutas unidades. Las células forman grandes.. La Biología es el estudio de los organismos vivos y de los procesos vitale s. Es fácil imaginar los organismos vivos, especialmente los que se ven a simple vista como un hombre o un árbol. Pero estos son sólo un ejemplo de los millones de seres vivos que se conocen, sin contar los que se cree que existen y aún no han sido descubiertos, y.

1. Microbiología

Observación de células

Imágenes microscópicas Forocoches

Cómo ver nuestras propias células al microscopio? Ver nuestras células

Las 23 partes de una célula (y sus funciones)

El microscopio presenta ¡La célula! velabco

BIOLOGÍA Y MÁS 1º ESO TEMA 5 PRÁCTICA 10 EL MICROSCOPIO ÓPTICO

Como Se Ve Una Celula En Un Microscopio Consejos Celulares

Práctica de laboratorio Observación de células en vivo YouTube

PENSANDO EN CIENCIAS NATURALES Células I

Imagen microscópica las células.

¿Por qué no es posible ver las células a simple vista o con una lupa?

Los 2 tipos de células que existen y sus características

Biología de Tercer Año La Célula como Unidad de Vida

CIENCIAS JPL ¿Qué estructuras se pueden observar en células de

Organismos unicelulares procariotas que no son visibles a simple vista

laboratorio 1 Caracteristicas estructurales de las celulas vegetales
Sample Mind Map Mind Map

¿Cómo son tus CÉLULAS? YouTube

La célula Introducción
Las células de los óvulos humanos, las bacterias inusualmente grandes, algunas amebas y las células nerviosas del calamar conforman esta lista. Algunas personas pueden pensar que los huevos de las especies que ponen huevos son células individuales, pero esa es una clasificación falsa. En general, los objetos más pequeños que el ojo.. Las células. Las células son los componentes básicos del cuerpo. Todos los tejidos y órganos están formados por miles de millones de células diferentes. El tamaño de las células humanas varía de unas a otras, pero todas son muy pequeñas. Incluso la mayor de todas, el óvulo fecundado, es tan pequeña que no es perceptible a simple vista.